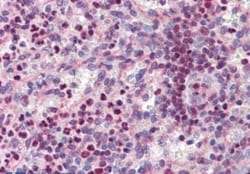
PU.1/Spi-1 Antibody, Novus Biologicals 0.1mg; Unlabeled:Antibodies, Polyclonal

missing translation for 'onlineSavingsMsg'
Learn More
Learn More
PU.1/Spi-1 Antibody, Novus Biologicals™
Goat Polyclonal Antibody has been used in 2 publications
Brand: Novus Biologicals NBP1-00135
This item is not returnable.
View return policy
Description
PU.1/Spi-1 Polyclonal specifically detects PU.1/Spi-1 in Human samples. It is validated for Western Blot, Flow Cytometry, Immunohistochemistry, Immunohistochemistry-Paraffin, Peptide ELISA.
Specifications
| PU.1/Spi-1 | |
| Polyclonal | |
| Unconjugated | |
| Tris saline (20 mM Tris pH 7.3, 150 mM NaCl), 0.5% BSA with 0.02% Sodium Azide | |
| hematopoietic transcription factor PU.1, OF, PU.1, SFPI131 kDa transforming protein, SPI-1, SPI-1 proto-oncogene, SPI-A, spleen focus forming virus (SFFV) proviral integration oncogene spi1,31 kDa-transforming protein, transcription factor PU.1 | |
| Goat | |
| Affinity Purified | |
| RUO | |
| Primary | |
| This antibody is expected to recognize both reported isoforms (NP_001074016.1; NP_003111.2). | |
| Store at -20C. Avoid freeze-thaw cycles. |
| Western Blot, Flow Cytometry, Immunohistochemistry (Paraffin), ELISA | |
| 0.5 mg/mL | |
| Western Blot 0.03 ug/ml, Flow Cytometry 1:10-1:1000, Immunohistochemistry-Paraffin, Peptide ELISA Detection limit 1:32000 | |
| NP_001074016.1 | |
| SPI1 | |
| Peptide with sequence C-DLYQRQTHEYY corresponding to internal region according to NP_001074016.1, NP_003111.2. | |
| 0.1 mg | |
| Innate Immunity | |
| 6688 | |
| Human | |
| IgG |
Product Content Correction
Your input is important to us. Please complete this form to provide feedback related to the content on this product.
Product Title
For Research Use Only
Spot an opportunity for improvement?Share a Content Correction